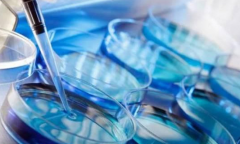
赤峰三大不孕不育医院，各具特色助力求子梦

试管医院

-
 收藏必备!大同顶尖三代试管私立医院精选!
收藏必备!大同顶尖三代试管私立医院精选!在当今社会,不孕不育困扰着众多夫妻,而试管技术的诞生为这些家庭重新点燃了生育的曙光。针对大同市,哪家私立医院在三代试管领域表现最优呢?本文将为您揭晓答案。
作者:盼盼 117 发布时间:2024-10-04 -
 九江三代试管服务比拼:哪家私立医院更出色?
九江三代试管服务比拼:哪家私立医院更出色?九江三代试管技术已相当成熟,它为那些渴望拥有孩子却因生殖系统问题难以自然受孕的夫妇提供了一个极佳的解决方案。但在决定前往私立医院进行三代试管之前,了解并选择一家优
作者:木易 94 发布时间:2024-10-04 -
 开封三代试管医院优选:顶尖医疗,助您好孕成真
开封三代试管医院优选:顶尖医疗,助您好孕成真现代医学技术日新月异,对于想要孩子的夫妇来说,如果自然受孕无效,试管技术成为他们的一种选择。而在开封市,有许多医院提供试管服务。但是在这些医院中,开封三代试管婴
作者:婷婷 136 发布时间:2024-08-16 -
 马来西亚三代试管医院有哪些?如何选择适合自己的试管医院?
马来西亚三代试管医院有哪些?如何选择适合自己的试管医院?在马来西亚有不少医院提供三代试管服务,但是每个医院的专业水平、设备状况、服务质量等都不同。因此在选择医院时需要认真比较分析。下面将为您推荐几家值得信赖的三代试管医院,并
作者:盼盼 71 发布时间:2024-08-16 -
 收藏!珠海三代试管医院制定个性化治疗方案
收藏!珠海三代试管医院制定个性化治疗方案在当今社会,不孕不育的问题越来越普遍,而试管技术则成为了解决这一问题的有效手段之一。作为粤港澳大湾区城市之一的珠海,拥有多家三代试管医院,在排名上也有所差异。本
作者:盼盼 165 发布时间:2024-08-16 -
赤峰三大不孕不育医院,各具特色助力求子梦
赤峰三大不孕不育医院,各具特色助力求子梦如果您和伴侣已经尝试了一段时间仍然无法怀孕,那么您可能正在寻找一个能够解决您问题的专业医疗机构。在赤峰,有许多不孕不育医院可供选择。但是哪家医院在这方面表现最好呢?下面我
作者:木易 102 发布时间:2024-08-15 -
 梧州工人医院试管之路:流程与三代试管费用全解析
梧州工人医院试管之路:流程与三代试管费用全解析试管是指通过辅助生殖技术将受精卵在体外培养后再植入母体的方法,是帮助不能自然受孕的夫妇实现生育愿望的一种选择。而成功率则是衡量试管过程中获得健康宝宝的指标之一。
作者:木易 115 发布时间:2024-08-15 -
 巢湖三代试管医院推荐:专业团队与先进技术,助您好孕
巢湖三代试管医院推荐:专业团队与先进技术,助您好孕随着科技的不断发展,试管已经成为许多不孕不育家庭的希望。而巢湖作为安徽省的一个重要城市,也拥有多家实力强大的试管医院。那么巢湖三代试管哪个医院好呢?下面我们将
作者:婷婷 114 发布时间:2024-08-15 -
 湖南三代试管医院榜单揭晓!中南大学湘雅医院技术领跑,备受信赖!
湖南三代试管医院榜单揭晓!中南大学湘雅医院技术领跑,备受信赖!湖南省三代试管医院名单的发布引起了广泛关注,对于那些希望通过辅助生殖技术实现怀孕的夫妇来说,这个名单是他们选择医院的重要参考。而2023年助孕成功率排名前三的医院更是备受
作者:wednesday 147 发布时间:2024-08-15 -
 泰国试管自助之旅全攻略:精选三家顶尖医院,助您好孕成真!
泰国试管自助之旅全攻略:精选三家顶尖医院,助您好孕成真!试管是一种较为常见的不孕不育治疗方式,而泰国则是一个备受欢迎的试管自助旅游圣地。本文将为大家介绍如何自助去泰国做试管,并提供实用的注意事项和医院推荐。 值得推
作者:婷婷 168 发布时间:2024-08-15 -
 济南试管医院大盘点!前五强医院名单+成功率,一看就懂!
济南试管医院大盘点!前五强医院名单+成功率,一看就懂!济南作为山东省的省会城市,拥有众多优质的医疗机构和助孕机构。那么在选择济南做试管的医院时,应该如何判断哪家好呢?根据2023年全国范围内的助孕机构成功率排名,我们可以从中得
作者:wednesday 123 发布时间:2024-08-15 -
 上海不孕不育医院排名前三强,助您实现生育梦想!
上海不孕不育医院排名前三强,助您实现生育梦想!随着现代社会的快节奏生活和环境污染的日益加重,越来越多的夫妻遭遇不孕不育问题。在上海这个国际化大都市,很多夫妻也在寻找专业、权威的不孕不育医生。那么上海哪家医院的不孕不
作者:婷婷 181 发布时间:2024-08-15
